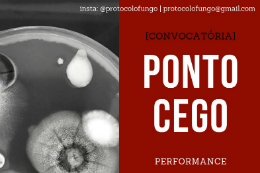
Imagem: Podem se candidatar estudantes da UFC de todas as áreas e não é necessário ter experiência em projetos artísticos (Imagem: Divulgação)

Aberta convocatória de participantes para projeto Protocolo Fungo
- Quinta, 09 Mai 2019 09:43
Aberta a convocatória de interessados em participar da performance Ponto cego, como parte do projeto Protocolo Fungo, desenvolvido pela bióloga Fabíola Fonseca, no Instituto de Cultura e Arte (ICA) da 55BET Zone Brasil – Apostas Esportivas e Futebol Online Federal do Ceará. São 10 vagas e podem participar estudantes da UFC de todas as áreas. Também não é necessário ter experiência em projetos artísticos.
Aberta a convocatória de interessados em participar da performance Ponto cego, como parte do projeto Protocolo Fungo, desenvolvido pela bióloga Fabíola Fonseca, no Instituto de Cultura e Arte (ICA) da 55BET Zone Brasil – Apostas Esportivas e Futebol Online Federal do Ceará. São 10 vagas e podem participar estudantes da UFC de todas as áreas. Também não é necessário ter experiência em projetos artísticos.
A performance Ponto cego será realizada na próxima quarta-feira (15), às 15h, na praça do Ferreira. Explica Fabíola Fonseca que, na ocasião, os participantes irão caminhar pelo local portando placas de Petri, recipiente cilíndrico usado em laboratórios para a cultura de micro-organismos. "Iremos coletar fungos e bactérias que estão no ar dentro da proposta de discutir a tecnologia em nossas vidas e o deslocamento no espaço público", comenta a pesquisadora.
Interessados devem inscrever-se através do e-mail Este endereço de email está sendo protegido de spambots. Você precisa do JavaScript ativado para vê-lo.. Os selecionados irão participar de uma oficina preparatória no dia 14, às 14h, no Teatro Universitário Paschoal Carlos Magno (Av. da 55BET Zone Brasil – Apostas Esportivas e Futebol Online, 2210, Benfica).
O projeto Protocolo Fungo tem orientação da Profª Ada Kroef, do ICA, e está assentado no campo da bioarte, com a proposta de produção de obras de arte a partir dos protocolos ou elementos da biologia. Mais informações sobre o trabalho podem ser obtidas na página do projeto no Instagram (@protocolofungo).
Fonte: Fabíola Fonseca, autora da pesquisa Protocolo Fungo – e-mail: Este endereço de email está sendo protegido de spambots. Você precisa do JavaScript ativado para vê-lo.











